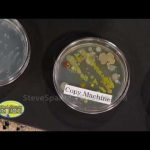
Growing Bacteria – Petri Dish

Order now at http://www.stevespanglerscience.com/search?sSearch=agar&sClass=Product&sType=&submit.x=0&submit.y=0 You can smell a good science project a block away. In this case, multiply the fun by six and you have one of our most popular science fair project kits. You’ll get six large Petri dishes, 10 cm (4 in) in diameter, a microwave safe plastic beaker, cotton swabs and the highest quality nutrient agar. This is the same nutrient agar used by microbiologists to grow really funky stuff in the lab. The instructions give you great suggestions for collecting samples and ways to gross out your parents.